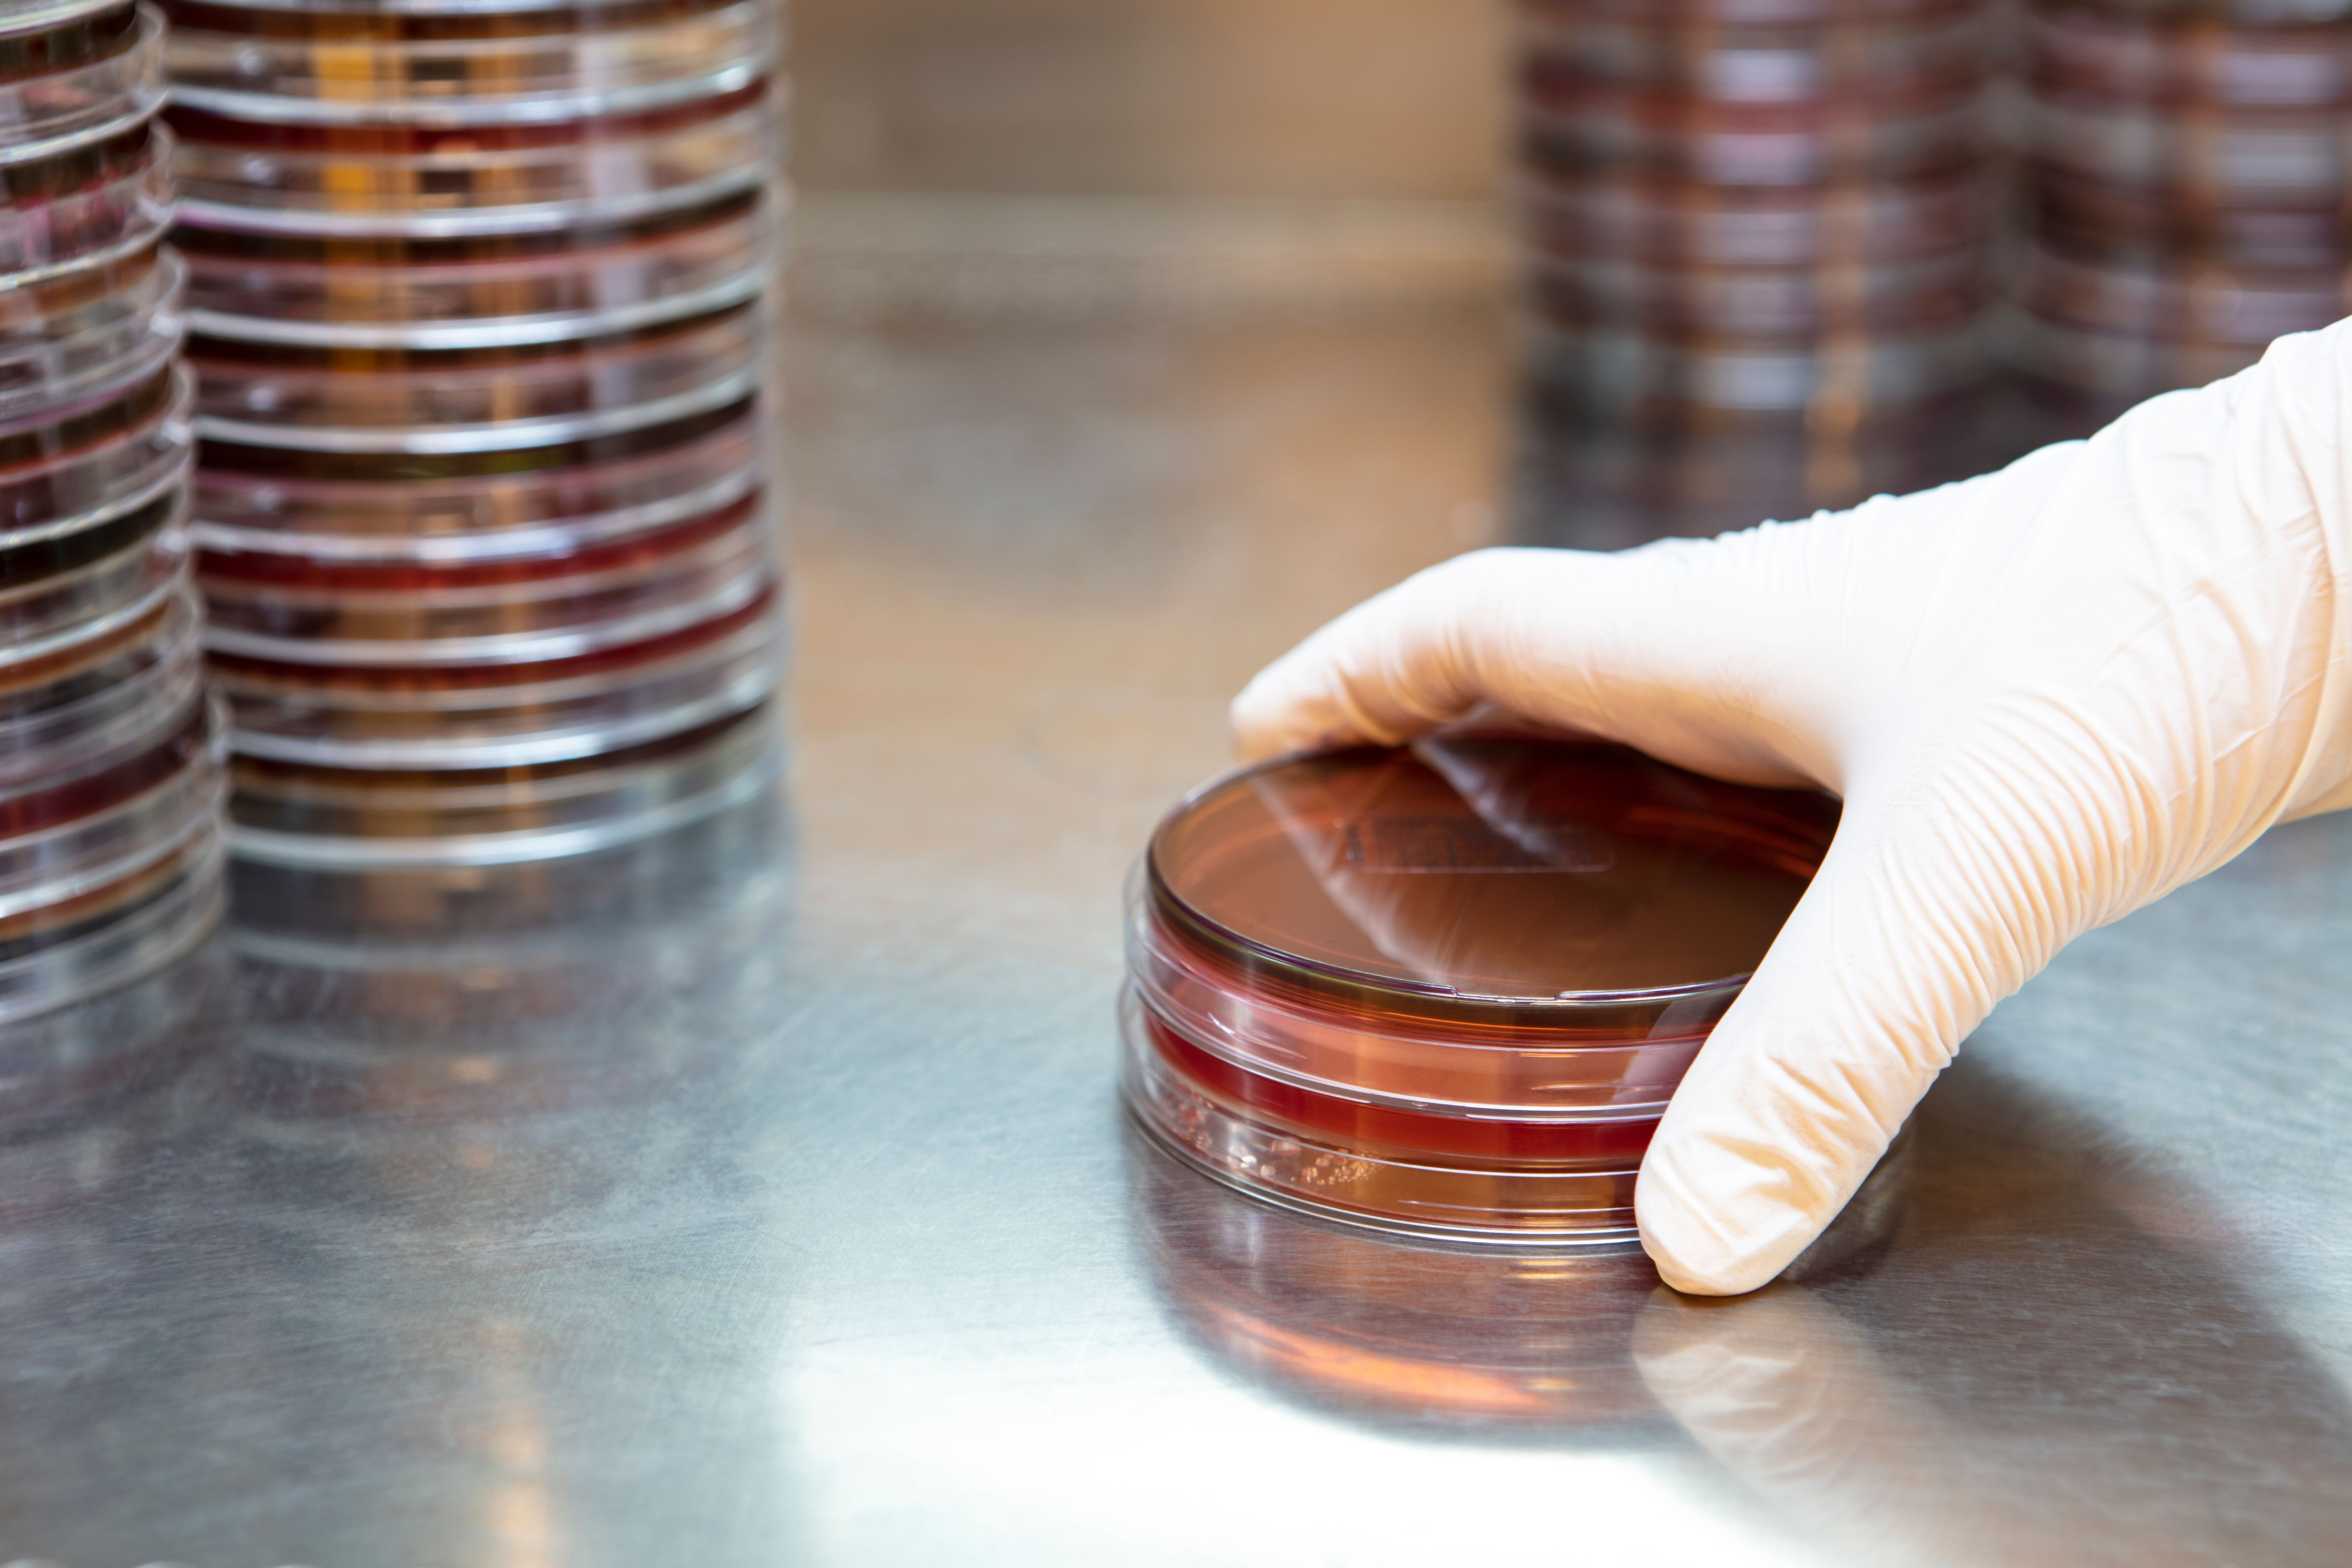
laminar air-flow

Myth-Busting: Common Misconceptions About Laminar Air-Flow Systems
Understanding Laminar Air-Flow Systems
Laminar air-flow systems are crucial in maintaining sterile environments, especially in medical and laboratory settings. Despite their importance, several misconceptions surround these systems. In this post, we aim to debunk some of the common myths and provide clarity on their functionality and benefits.
Myth 1: Laminar Air-Flow Systems Are Only Used in Hospitals
While hospitals are a primary user of laminar air-flow systems, their application extends far beyond healthcare. These systems are essential in various industries including pharmaceuticals, electronics manufacturing, and even food processing. Any environment requiring controlled air quality can benefit from these systems.
In the electronics industry, for example, laminar air-flow helps prevent contamination of sensitive components during assembly. Similarly, in the food industry, it maintains hygiene standards during packaging processes.

Myth 2: All Laminar Air-Flow Systems Are the Same
This misconception often leads to confusion when selecting the right system for specific needs. Laminar air-flow systems come in different configurations, such as vertical and horizontal flow. Each type serves distinct purposes and is suitable for different environments.
Vertical flow systems direct air from the top to the bottom, making them ideal for applications where contaminant control from above is crucial. Horizontal flow systems, on the other hand, push air from the back of the unit to the front, which is useful in settings where space is limited.

Myth 3: They Are Too Expensive to Install and Maintain
While it's true that installing laminar air-flow systems requires an initial investment, the cost is often justified by the benefits. Improved air quality can lead to higher product yields, reduced contamination incidents, and a safer working environment. Many systems are also energy-efficient, helping to lower operational costs over time.
Regular maintenance is essential to ensure optimal performance, but it is not as burdensome as some might think. Most systems require only periodic filter replacements and basic cleaning, making them cost-effective in the long run.

Myth 4: Laminar Air-Flow Systems Eliminate All Contaminants
Although highly effective, laminar air-flow systems do not guarantee the elimination of all contaminants. They are designed to minimize airborne particles and provide a clean airflow, but other measures are often necessary to achieve a completely sterile environment.
Combining laminar air-flow with other practices such as regular surface cleaning, proper gowning, and adherence to cleanliness protocols is essential for maximum contamination control.
Conclusion: Making Informed Decisions
Understanding the truth about laminar air-flow systems helps in making informed decisions regarding their implementation. By dispelling these myths, we hope to highlight the versatility, affordability, and effectiveness of these systems in various industries.
Investing in the right laminar air-flow system can significantly enhance the quality and safety of your operations, ensuring compliance with industry standards and protecting both products and personnel.
